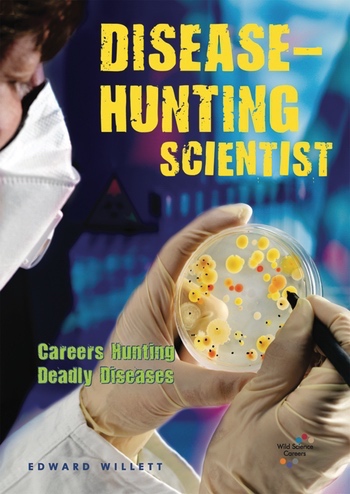

Top menu
- Call Toll Free (800) 398-2504 M–F 9am–6pm EST
- Fax (877) 980-4454
- Find a Rep
- Need Help?
Js and css
Custom styles
Block as products carousel:



Enslow Publishing offers a plethora of award-winning fiction and nonfiction titles for children and teenagers that have been recognized by the American Library Association, the NAACP, the National Council for the Social Studies, and the Society of School Librarians International.
The Rosen Publishing Group reserves all Large Language Model and Small Language Model-related rights.
Please contact The Rosen Publishing Group with licensing inquiries.
© 2026 Enslow Publishing. All Rights Reserved.
2544 Clinton St, Buffalo, NY 14224